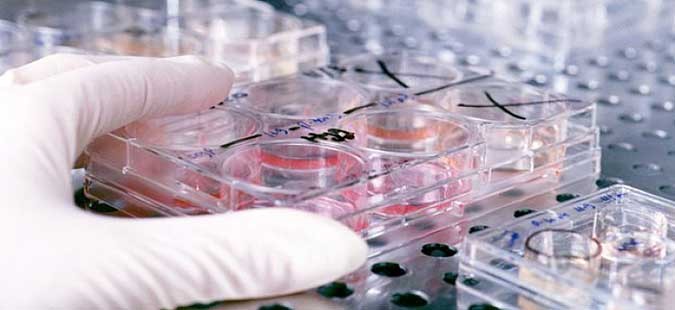

Уапсен вработен во македонска лабораторија и негов бугарски колега
Објавено во: Македонија 16 Април, 2022 10:11
Македонец и Бугарин, вработени во лаборатории, вчера биле приведени во дворот на Здравствен дом „Гоце Делчев“ во Делчево, откако биле фатени како разменуваат медиицински материјал.
Тие допатувале во Делчево со службени возила на лаборатории од Скопје и Бугарија, каде што биле вработени, при што биле затекнати како вршат размена на медицински материјал.
При претресот во возилото на бугарскиот државјанин Д.К.И. била пронајдена и одземена ќеса со повеќе епрувети наполнети со течност.
„За случајот е известен Јавен обвинител и по негово целосно расчистување и документирање ќе биде поднесена соодветна пријава“, објавија од МВР.
Не е познато дали приведениот од Скопје е вработен во државна или приватна лабораторија, ниту што содржеле запленетите епрувети.
Можеби ќе ве интересира
ФАКТОР НА ДЕНОТ: Надминат прагот на загадување во повеќе општини, издадени се препораки

ПРЕПОРАКА: Бремените и хронично болните да се ослободуваат од работа

(ВИДЕО) Русковска го пријавила Боки 13 во полиција за телефонско вознемирување

Мицкоски за реакцијата на грчкото МНР: За мене Македонија е свето име

Двајца затаиле данок од над еден милион евра од трговија со злато и накит, обвинителството бара притвор

Пријава од полиција: Кандидат за градоначалник давал по 1.000 денари за да се гласа за него

ГОТОВ Е ОБДУКЦИСКИОТ НАОД НА ПОЧИНАТОТО НОВОРОДЕНЧЕ: Причина за смртта е незрелост на белодробието

ВМРО-ДПМНЕ ИЗГЛАСАЛЕ ИЗМЕНИ НА ЗАКОНОТ ЗА СТРАНЦИ: Кузеска тврди тоа е за потребите на стратешкиот договор, за стратешки проекти

Надминат прагот на загадување во Центар, Гази Баба, Карпош, Лисиче и Ректорат, објавени мерки и препораки

















